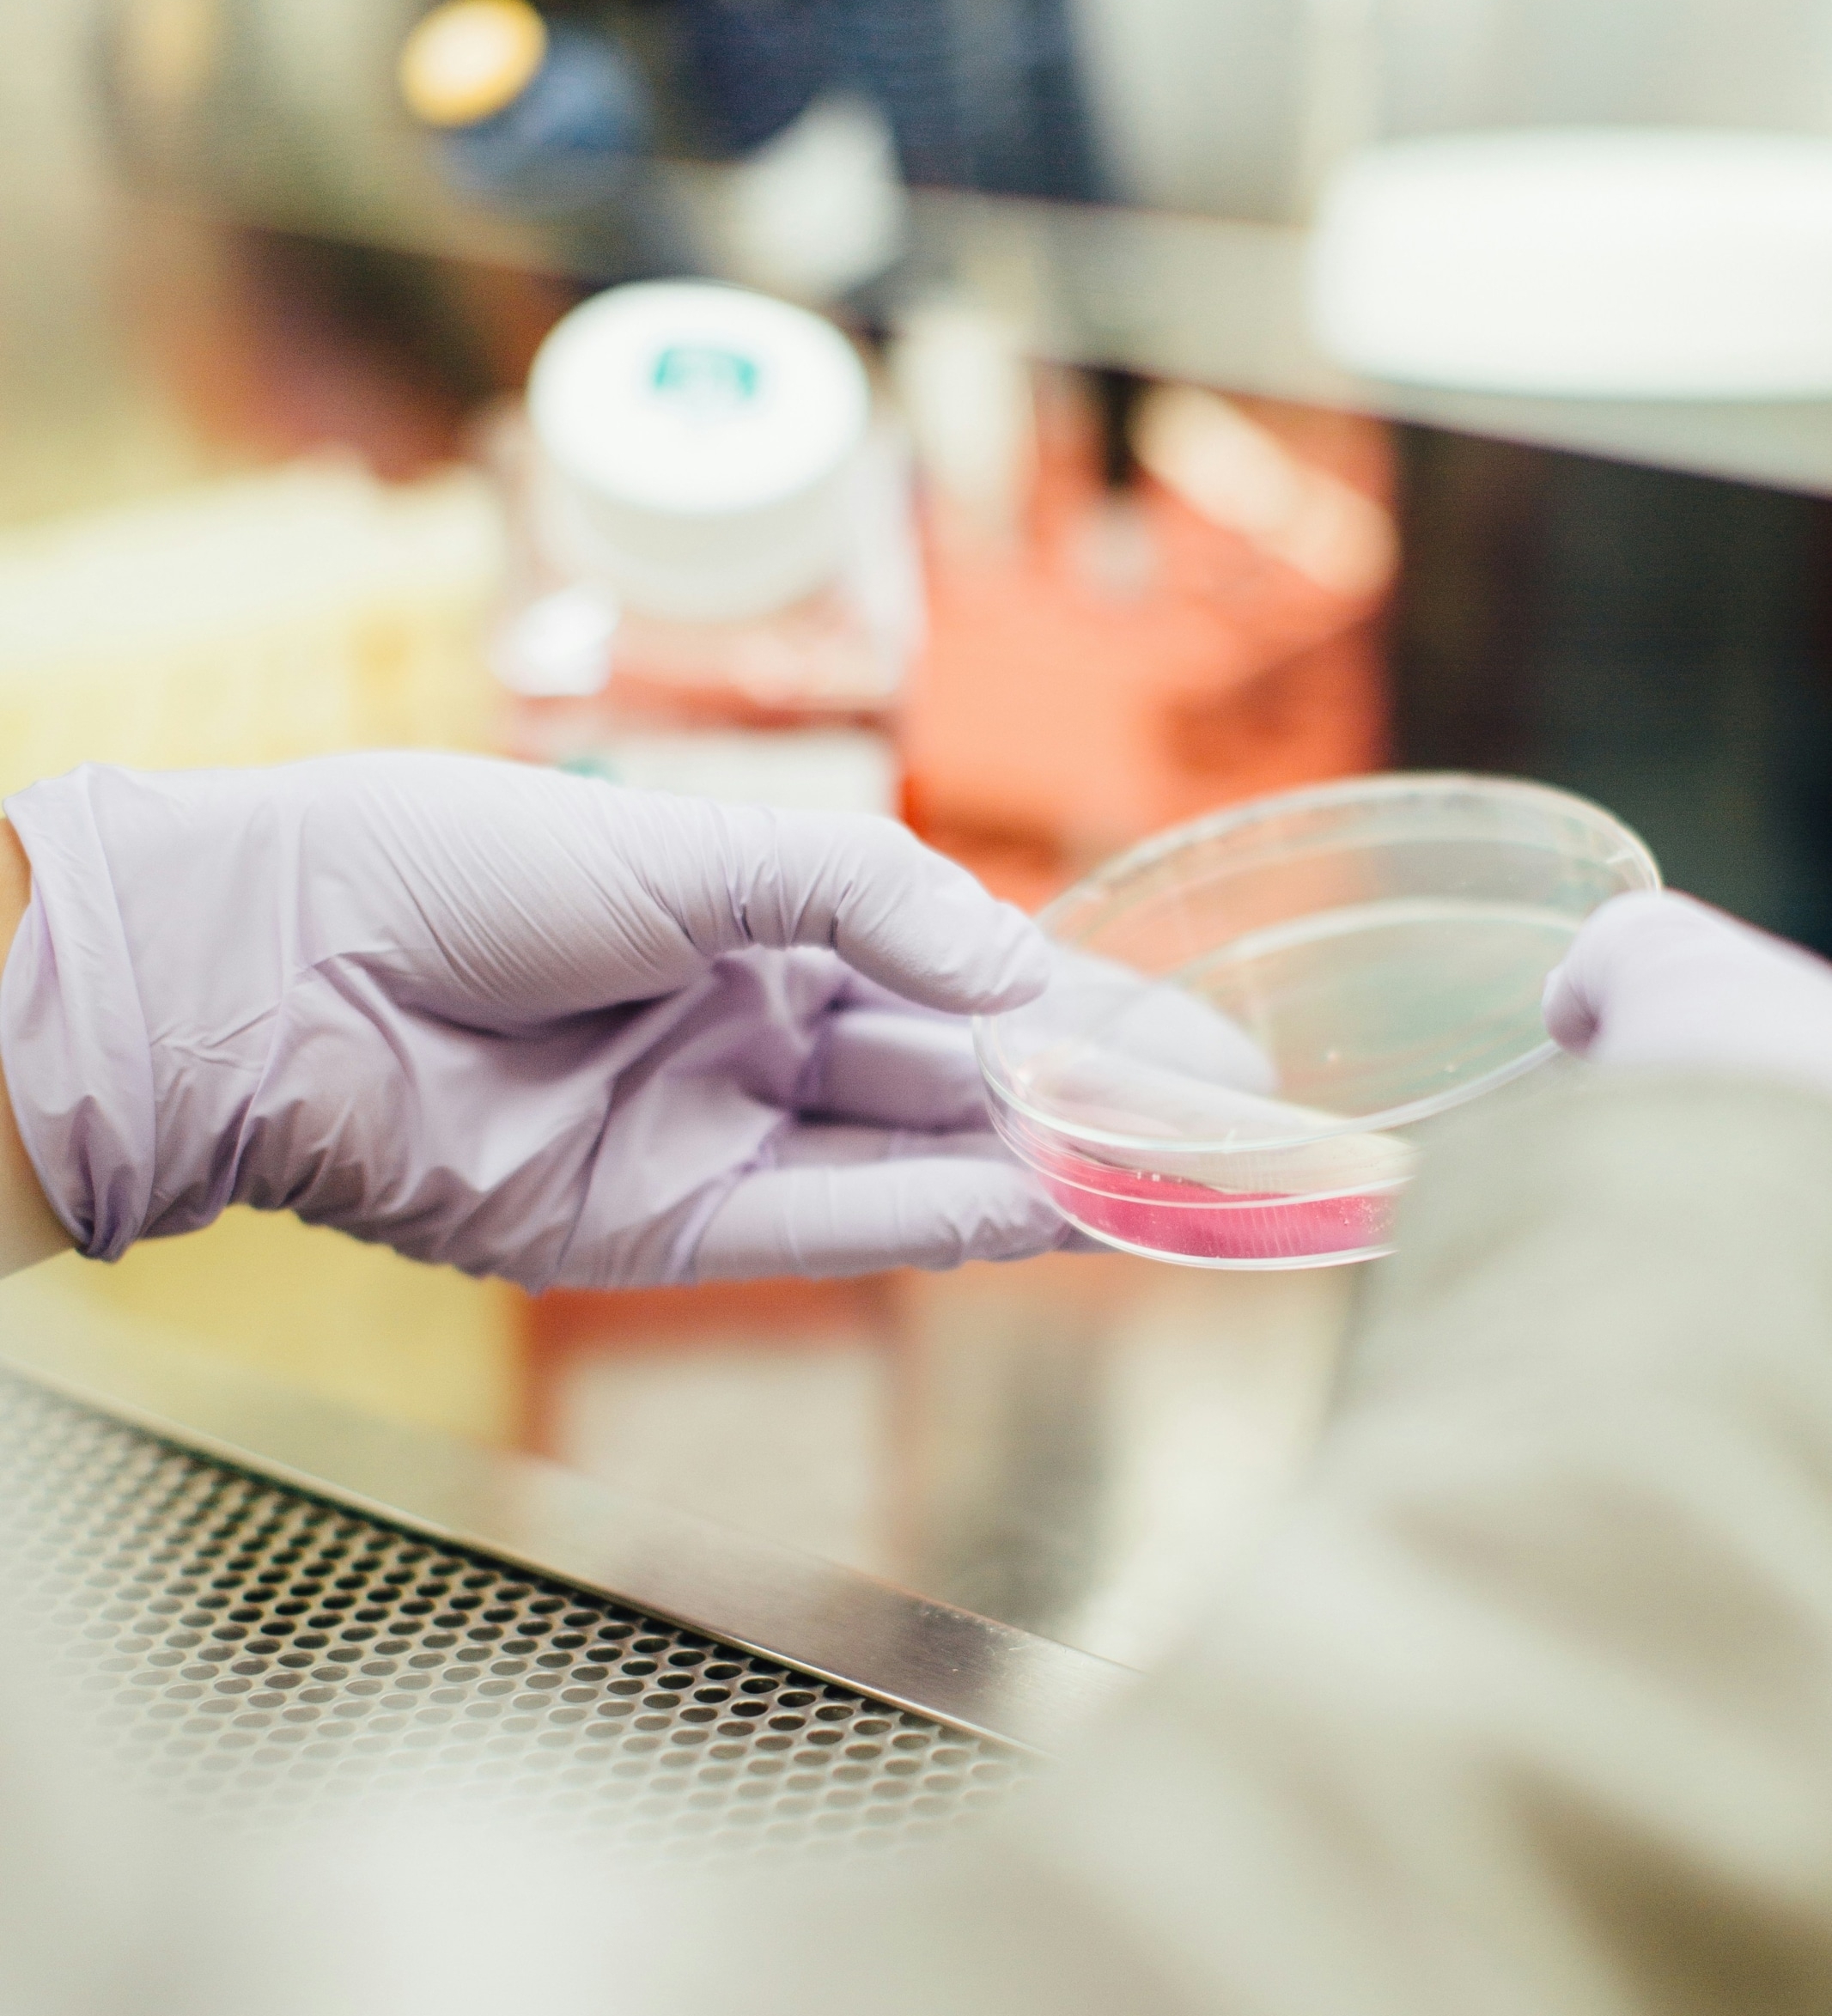

SAXS for Biostructural Research
In biostructural research, understanding how proteins, nucleic acids, lipids, and self-assembled biomaterials behave in solution is essential. Indeed, their function depends on nanoscale properties such as shape, oligomeric state, flexibility, and supramolecular organization. Many biologically relevant systems, whether well-folded proteins, multi-domain assemblies, intrinsically disordered regions, RNA architectures, or lipid-based nanostructures, are dynamic, heterogeneous, or difficult to crystallize. Characterizing these structures under near-physiological conditions is therefore critical for applications ranging from protein formulation and drug delivery to the design of advanced biomaterials.
Small-Angle X-ray Scattering (SAXS) provides a direct window into biomolecular structure in solution, quantifying global shape, oligomeric state, flexibility, and interactions without labels, staining, or crystallization. This makes SAXS particularly powerful for studying systems that are sensitive to sample preparation or that undergo structural transitions in response to formulation, ligand binding, or environmental changes. Beyond overall structure, SAXS can detect early aggregation events, resolve self-assembled biomolecular architectures, and reveal the internal organization of lipid, micellar, or peptide-based systems that underpin modern therapeutic development and formulation research.
Questions you can answer with SAXS for Biostructural Research
What are the size, molecular weight, and folding state of my protein or protein complex in solution?
Under which conditions does my protein remain stable, and when does it begin to aggregate or form higher-order assemblies?
What conformational ensemble and degree of flexibility do my intrinsically disordered proteins (IDPs) or RNA adopt in solution?
What is the nanostructure and phase organization of lipid-based drug delivery systems, surfactant assemblies, or micelles?
How do peptides or biological macromolecules self-assemble into fibrils, nanotubes, or biomaterial scaffolds, and what governs these pathways?
Which buffer and precipitant conditions maintain my protein in a well-folded, monodisperse state compatible with crystallization, and which promote unwanted aggregation?











